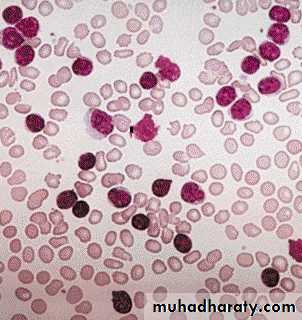
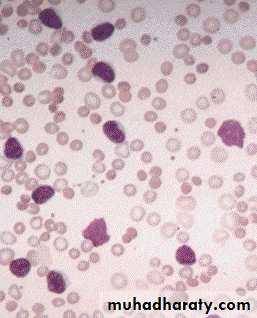
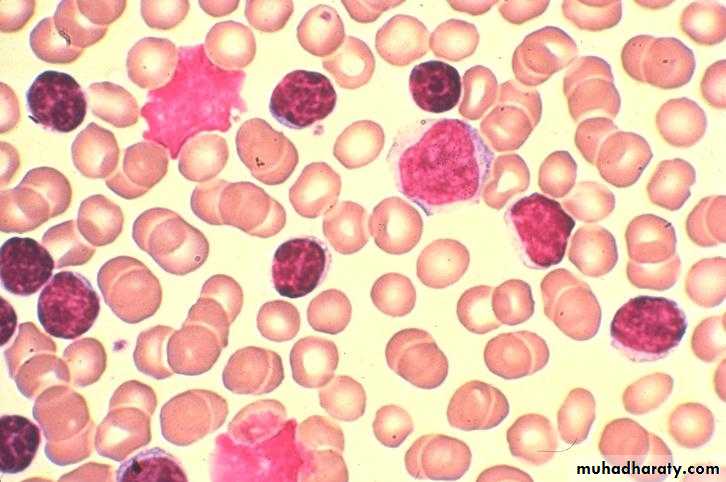
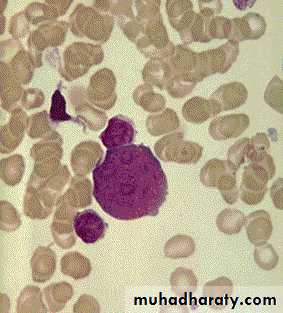
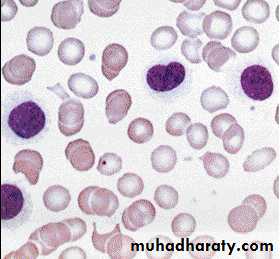

CLL; Axillary LAP
HSM with purpura & ecchymosiisCLL; Herpes zoster
Buccal Cavity: Candida albicansPBF in CLL: Small mature appearing lymphocytes with compact chromatin and scanty cytoplasm
Smudge cells
Spherocytes in AIHA
CLL; BF
CLL/PLRichter Transformation (BF)
Richter Transformation (LN)Prolymphocytic leukemia PLL; BF
Hairy Cell leukemia HCL; BF